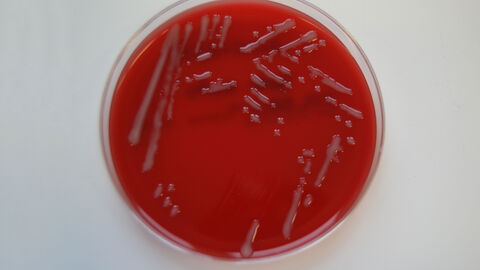

Erreger:
Pasteurella multocida ist ein gramnegatives, fakultativ anaerobes, nicht sporenbildendes Stäbchenbakterium aus der Familie der Pasteurellaceae. Der Erreger kann im feuchten Erdreich und Wasser überleben. Klinisch oder symptomlos (latent) infizierte Tiere gelten als Erregerreservoir, die den Erreger auf der Nasen-Rachenschleimhaut oder in den Tonsillen beherbergen und besonders unter Stresssituationen ausscheiden. Die Tiere infizieren sich oral durch direkten Kontakt (Speichel, Urin, Kot, Milch), über die Luft oder durch eine mit dem Erreger kontaminierte Umwelt (z. B. im Stall). Aufgrund einer geringen Widerstandskraft in der Umwelt (Tenazität) besitzt das Bakterium jedoch eine kurze Überlebensfähigkeit außerhalb eines Wirtstieres.
Von der primären Pasteurellose muss die in Deutschland häufig im Atmungstrakt gesunder und an Lungenentzündung leidender Tiere vorkommende sekundäre Pasteurellose mit Pasteurella multocida Kapseltyp A unterschieden werden. Dieser tritt als Sekundärerreger im Rahmen der enzootischen Bronchopneumonie (Lungenentzündung) bei Wiederkäuern und Schweinen auf und führt in vielen Beständen ebenfalls zu großen Problemen mit plötzlichen Todesfällen. Wie der Name vermuten lässt, ist hier die Rolle von Pasteurella multocida nur sekundär und es braucht begünstigende Umweltfaktoren und weitere virale oder bakterielle Erreger wie BHV-1-, PI3-, BRSV- oder BVD-Viren, Mannheimia haemolytica, Mycoplasma bovis, Pseudomonas aeruginosa, Trueperella pyogenes, Histophilus somni oder Bibersteinia trehalosi.
Krankheitsbild:
Es handelt sich meist um eine akut bis perakut tödlich verlaufende Allgemeininfektion des Tieres, die neben Rindern auch bei Wasserbüffeln sowie Reh-, Rot- und Schwarzwild auftritt. Aber auch kleine Wiederkäuer, Bisons, Antilopen, Schweine, Pferde, Esel, Zebras, Dromedare und Elefanten können in seltenen Fällen erkranken. Als klinische Symptome treten hohes Fieber, Schwellungen im Kopf- und Halsbereich sowie multiple Blutungen und blutiger Durchfall auf. Darüber hinaus ist aber auch das Auftreten von Schwäche und Atemnot beschrieben. Die Zeit zwischen Ansteckung und Ausbruch der Erkrankung (Inkubationszeit) beträgt nach Angaben der Weltorganisation für Tiergesundheit (WOAH) bis zu 90 Tage (oft aber lediglich 1-5 Tage) und verläuft meist innerhalb von wenigen Stunden oder Tagen nach Ausbruch tödlich. Die Sterblichkeitsrate (Mortalität) liegt zwischen 50 und 100 %.
Vorkommen:
Die Hämorrhagische Septikämie tritt besonders in tropischen und subtropischen Ländern örtlich begrenzt auf. In Europa sind nur vereinzelte Fälle bei Haus- und Wildtieren berichtet worden. Seit 1969 gilt die HS in Deutschland nicht mehr als anzeigepflichtige Tierseuche und wird nicht staatlich bekämpft. Ebenso besteht keine Meldepflicht. Bei der WOAH ist diese Seuche aber noch als meldepflichtige Tierkrankheit gelistet.
Seit Ende der Anzeigepflicht gab es in Deutschland lediglich einzelne Nachweise in Baden-Württemberg, Bayern, Brandenburg, Mecklenburg-Vorpommern, Niedersachsen, Sachsen-Anhalt bei den Tierarten Rind, Schwein und Damwild mit zeitlich und räumlich begrenzten Ausbrüchen.
Aktueller Nachweis in Hessen:
Im Juli 2023 wurde ein plötzlich verstorbenes Jungrind aus einer Mutterkuhhaltung in Hessen zur Sektion an das Hessische Landeslabor verbracht. Laut Vorbericht gab es in dem Betrieb zuvor bereits mehrere ungeklärte Todesfälle bei Jungrindern. Diese Tiere waren im Alter von 3-6 Monaten innerhalb weniger Tage ohne klinische Anzeichen akut verendet. Das zur Sektion eingesandte Tier zeigte zuvor einen steifen, schwankenden Gang, bevor es ebenfalls verstarb.
Im Rahmen der pathologisch-anatomischen Untersuchung wurde u.a. eine hochgradige, akute, diffuse Bauchfellentzündung (Peritonitis) mit Verklebung des Darms festgestellt. Zudem lag eine mittelgradige, akute, diffuse Brustfellentzündung (Pleuritis) vor. Die Milz war hochgradig geschwollen.